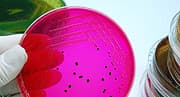
Understanding the War in Your Gut

A new study has demonstrated that consistent intake of grape seed extract1 is the best way to get it into your brain. The reason you want it in your brain is because it is a powerful antioxidant and anti-inflammatory nutrient (modulating the gene signal NF-kappaB). It is being widely studied for the prevention and treatment of cognitive decline and Alzheimer's disease.
The study showed that a single dose, even a single large dose did not enter the brain. However, consistent daily intake showed up in the brain within ten days. The higher the dose, the greater the brain levels of this novel and important brain-helping nutrient.
Consistent Intake of Grape Seed Extract is Best for Your Brain
Byron J. Richards, Board Certified Clinical Nutritionist